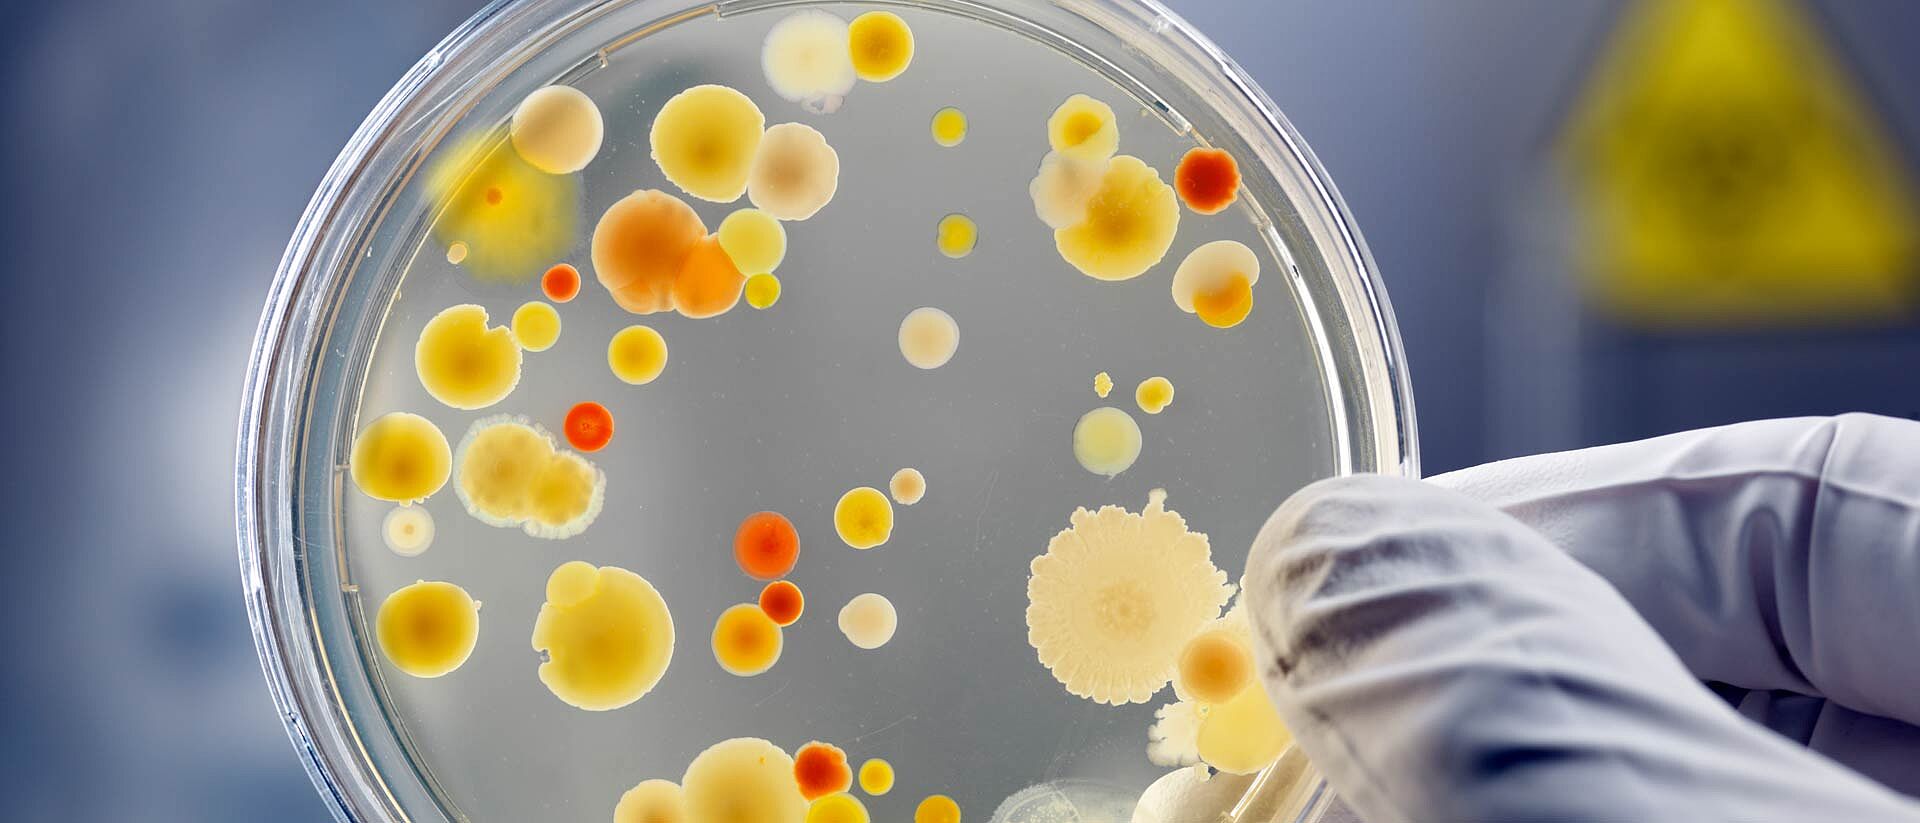

Antibacterial according to ISO 22196
Hohenstein Laboratories tests the sample in accordance with the ISO 22196 standard "Measurement of antibacterial activity on plastics and other non-porous surfaces."
The quality label confirms that the sample demonstrates antibacterial activity against the bacterial test strains Staphylococcus aureus ATCC 6538 and Escherichia coli ATCC 8739.
The antibacterial activity of the test sample must show at least a germ reduction of 2 lg steps (= 99 %) for both test strains compared to a control material. The quality label is based on a test report with detailed results.